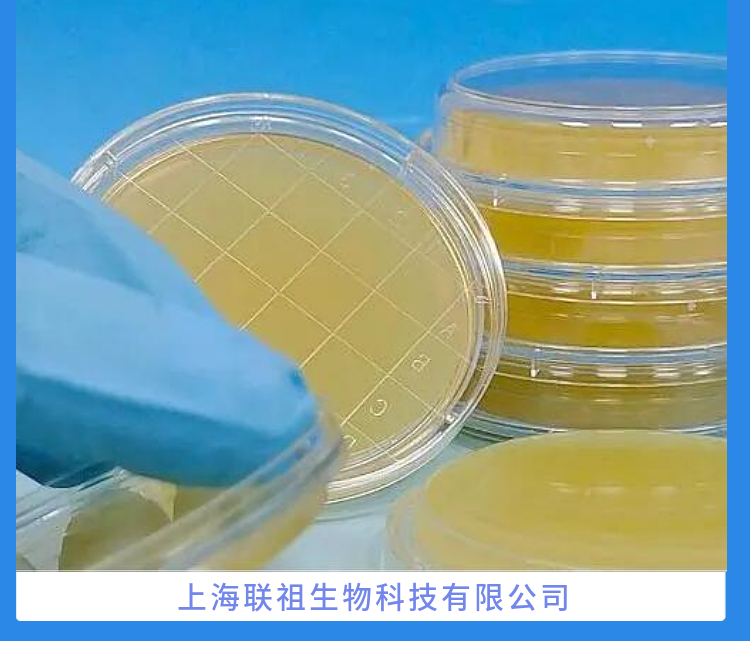
IPTG干粉(蓝白斑筛选用)(诱导表达用)
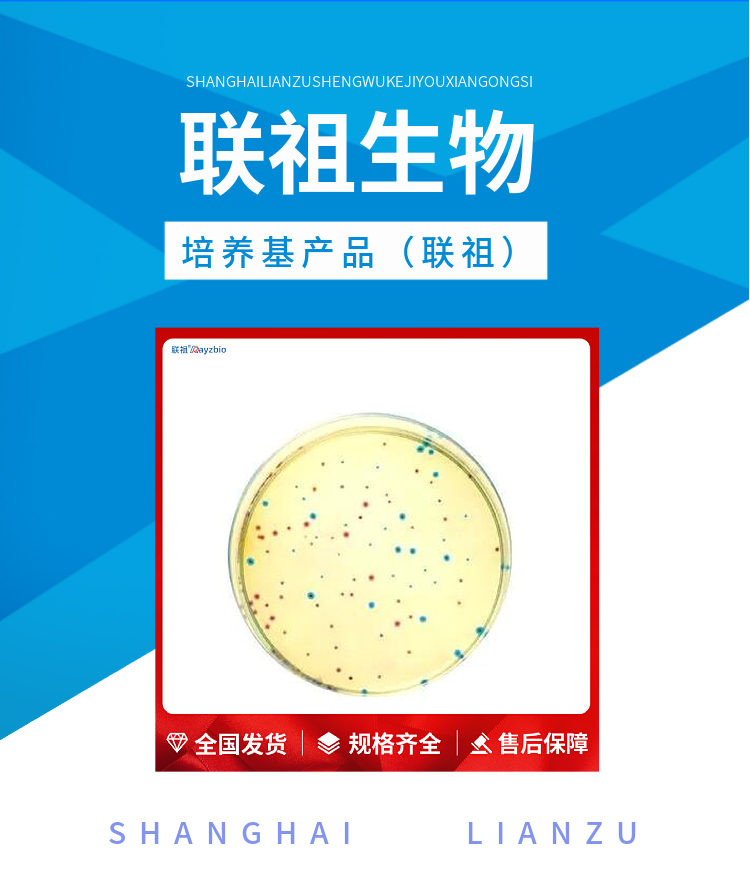
IPTG干粉(蓝白斑筛选用)(诱导表达用)

相关产品推荐更多 >
万千商家帮你免费找货
0 人在求购买到急需产品
- 详细信息
- 文献和实验
- 技术资料
- 库存:
33
- 英文名:
IPTG
- 供应商:
上海联祖
- 规格:
1g|5g

| 中文名称 | IPTG干粉(蓝白斑筛选用)(诱导表达用) | 英文名称 | IPTG |
| 产品规格 | 1g|5g | 发货周期 | 1~3天 |
| 货号 | LZ-PYJ4915 | 用途 | 仅供科研实验 |

本产品为接近白色的粉末,常用于蓝白斑筛选及IPTG诱导的细菌内的蛋白表达等,通常用水配制成0.1M或20%的储备液,是常用分子生物学试剂。
英文名称:Isopropyl β-D-thiogalactoside
CAS:367-93-1
分子式:C9H18O5S
分子量:238.30
等级:超纯级
纯度:>99%
储存条件:-20℃。

简便 大多数无需高压灭菌即可使用
特异 目标菌落色泽鲜艳,易于辨识
可靠 经大量分离株验证,符合率高
快速 最快检测时间为24h
节省 大批量样本的处理和检测,可减少补充生化试验的时间和费用
标准化 显色培养基已经普遍得到FDA、AOAC等国外官方的认可,被逐步引入到各种国际和国家检验标准中

一、培养基颜色不正确
(1)含有酸碱指示剂的培养基,若颜色不正确,通常是由于pH不正确导致的,加热过度、错误的灭菌方式等都会导致此项问题。
(2)加热过度导致某些成分分解或糖焦化,如SC培养基(SC增菌液)加热过度会变红,含糖量高的培养基,加热过度通常会出现颜色加深,呈焦糖色或棕褐色。
(3)某些成分变质,如血液久置易变黑,制成的平板颜色偏棕黑色。
二、 培养基不凝固或凝固性差
(1)称量错误
(2)琼脂分布不均匀
(3)培养基pH不正确
(4)加热过度
(5)琼脂量不足
三、培养基产生沉淀
(1)某些培养基原本就含有不溶性沉淀,如TTB,MC培养基等,配方中含有大量不溶性碳酸钙。
(2)灭菌前未充分溶解,如Fraser培养基中含有大量磷酸盐,若灭菌前溶解不充足,灭菌后就会出现大量沉淀。
(3)pH不正确,偏酸或偏碱都有可能使培养基中的部分金属离子产生沉淀。
(4)水的纯度不够,天然水中含有较多的矿物盐离子,若未除净,则易与培养基中的磷酸盐反应生成沉淀。
(5)添加剂加入温度不正确,卵黄、血液等对温度敏感的添加成分,若加入时温度过高或温差过大,易出现凝块。
(6)称量错误。
(7)试剂加入顺序不正确。

Calicin蛋白(CCIN)ELISA试剂盒Calicin(CCIN)ELISA Kit
Apelin受体(APLNR)ELISA试剂盒Protein Kinase, AMP Activated Alpha 1(PRKAa1)ELISA Kit
Ⅲ型胶原α1(COL3α1)ELISA试剂盒3-Hydroxybutyrate Dehydrogenase 1(BDH1)ELISA Kit
43kDa核孔蛋白(NUP43)ELISA试剂盒Human TNFAIP6 ELISA Kit
人CD14分子ELISA⤤듈⤤
人酶9ELISA试剂盒Human carbonic anhydrase 9 ELISA Kit,carbonic anhydrase 9,CA-9
人细胞角蛋白18ELISA试剂盒Human cytokeratin 18 ELISA Kit,cytokeratin 18,CK-18
人血管内皮生长因子BELISA试剂盒Human Vascular Endothelial cell Growth Factor B ELISA Kit,Vascular Endothelial cell Growth Factor B,VEGF-B
人胰高血糖素样肽1ELISA试剂盒Human ghcagons-like pepfide 1 ELISA Kit,ghcagons-like pepfide 1,GLP-1
人中性粒细胞弹性蛋白酶ELISA试剂盒Human neutrophil elastase ELISA Kit,neutrophil elastase,NE
人柯萨奇病毒ELISA试剂盒Human Coxsackie virus ELISA Kit,Coxsackie virus,CoxV
5羟色胺转运蛋白(SERT)ELISA试剂盒Human Transforming growth factor-beta-induced protein ig-h3,TGFBI/BIGH3 ELISA kit
人apelin 36ELISA试剂盒Human apelin 36 ELISA Kit,apelin 36,AP36
人Toll样受体9ELISA试剂盒Human Toll-like receptor 9 ELISA Kit,Toll-like receptor 9,TLR9
人白细胞介素2ELISA⤤듈⤤
人去乙酰化酶Sirtuin-2ELISA试剂盒Human NAD-dependent deacetylase sirtuin-2 ELISA Kit,NAD-dependent deacetylase sirtuin-2,SIRT2
人卵泡抑素样蛋白1ELISA试剂盒Human Follistatin Like Protein 1 ELISA Kit,Follistatin Like Protein 1,FSTL1
人乙二醛酶ⅠELISA试剂盒Human GlyoxalaseⅠ ELISA Kit,Gly⤤듈⤤
IPTG干粉(蓝白斑筛选用)(诱导表达用)SD肉汤培养基(五缺Ade/His/Leu/Trp/Ura) SD/-Ade/-His/-Leu/-Trp/-Ura Broth 10×500mL
DO Supplement(双缺:His/Met) Dropout Supplement -His/-Met 20g
SC/-Ade/-His/-Leu/-Trp Broth SC/-Ade/-His/-Leu/-Trp Broth 5L
风险提示:丁香通仅作为第三方平台,为商家信息发布提供平台空间。用户咨询产品时请注意保护个人信息及财产安全,合理判断,谨慎选购商品,商家和用户对交易行为负责。对于医疗器械类产品,请先查证核实企业经营资质和医疗器械产品注册证情况。
 文献和实验
文献和实验状态.此时,I序列在PI启动序列操纵下表达的Lac阻遏蛋白与O序列结合,阻碍RNA聚合酶与P序列结合,抑制转录起动. 当有乳糖存在时,lac操纵子(元)即可被诱导.在这个操纵子(元)体系中,真正的诱导剂并非乳糖本身.乳糖进入细胞,经b-半乳糖苷酶催化,转变为半乳糖.后者作为一种诱导剂分子结合阻遏蛋白,使蛋白构象变化,导致阻遏蛋白与O序列解离、发生转录.异丙基硫代半乳糖苷(IPTG)是一种作用极强的诱导剂,不被细菌代谢而十分稳定,因此被实验室广泛应用. 材料: 1、诱导表达
酶基因的菌株 ⑤诱导表达目的蛋白 SDS-PAGE,Western 印迹、定量分析确定目的蛋白 ⑥放大试验纯化目的蛋白 放大试验,制备粗提物,亲和纯化,切除融合标签 2)配制生长培养基如LB,和100mM IPTG,50μg/ml 卡那霉素存储液. 3)宿主菌的保存.长期存放菌株和pET重组子应保存于甘油中. 4)感受态细胞的制备,参照其它试验手册. 2.操作步骤 [1] 制备载体 1)载体消化和胶纯化
【实验报告要求与思考题】 1.对紫外灯下观察到的结果作出解释。 2.为什么诱导表达的大肠杆菌要在其OD600浓度约为0.5时加入IPTG? 3.大肠杆菌的诱导表达常受哪些因素的影响?
 技术资料
技术资料暂无技术资料 索取技术资料









